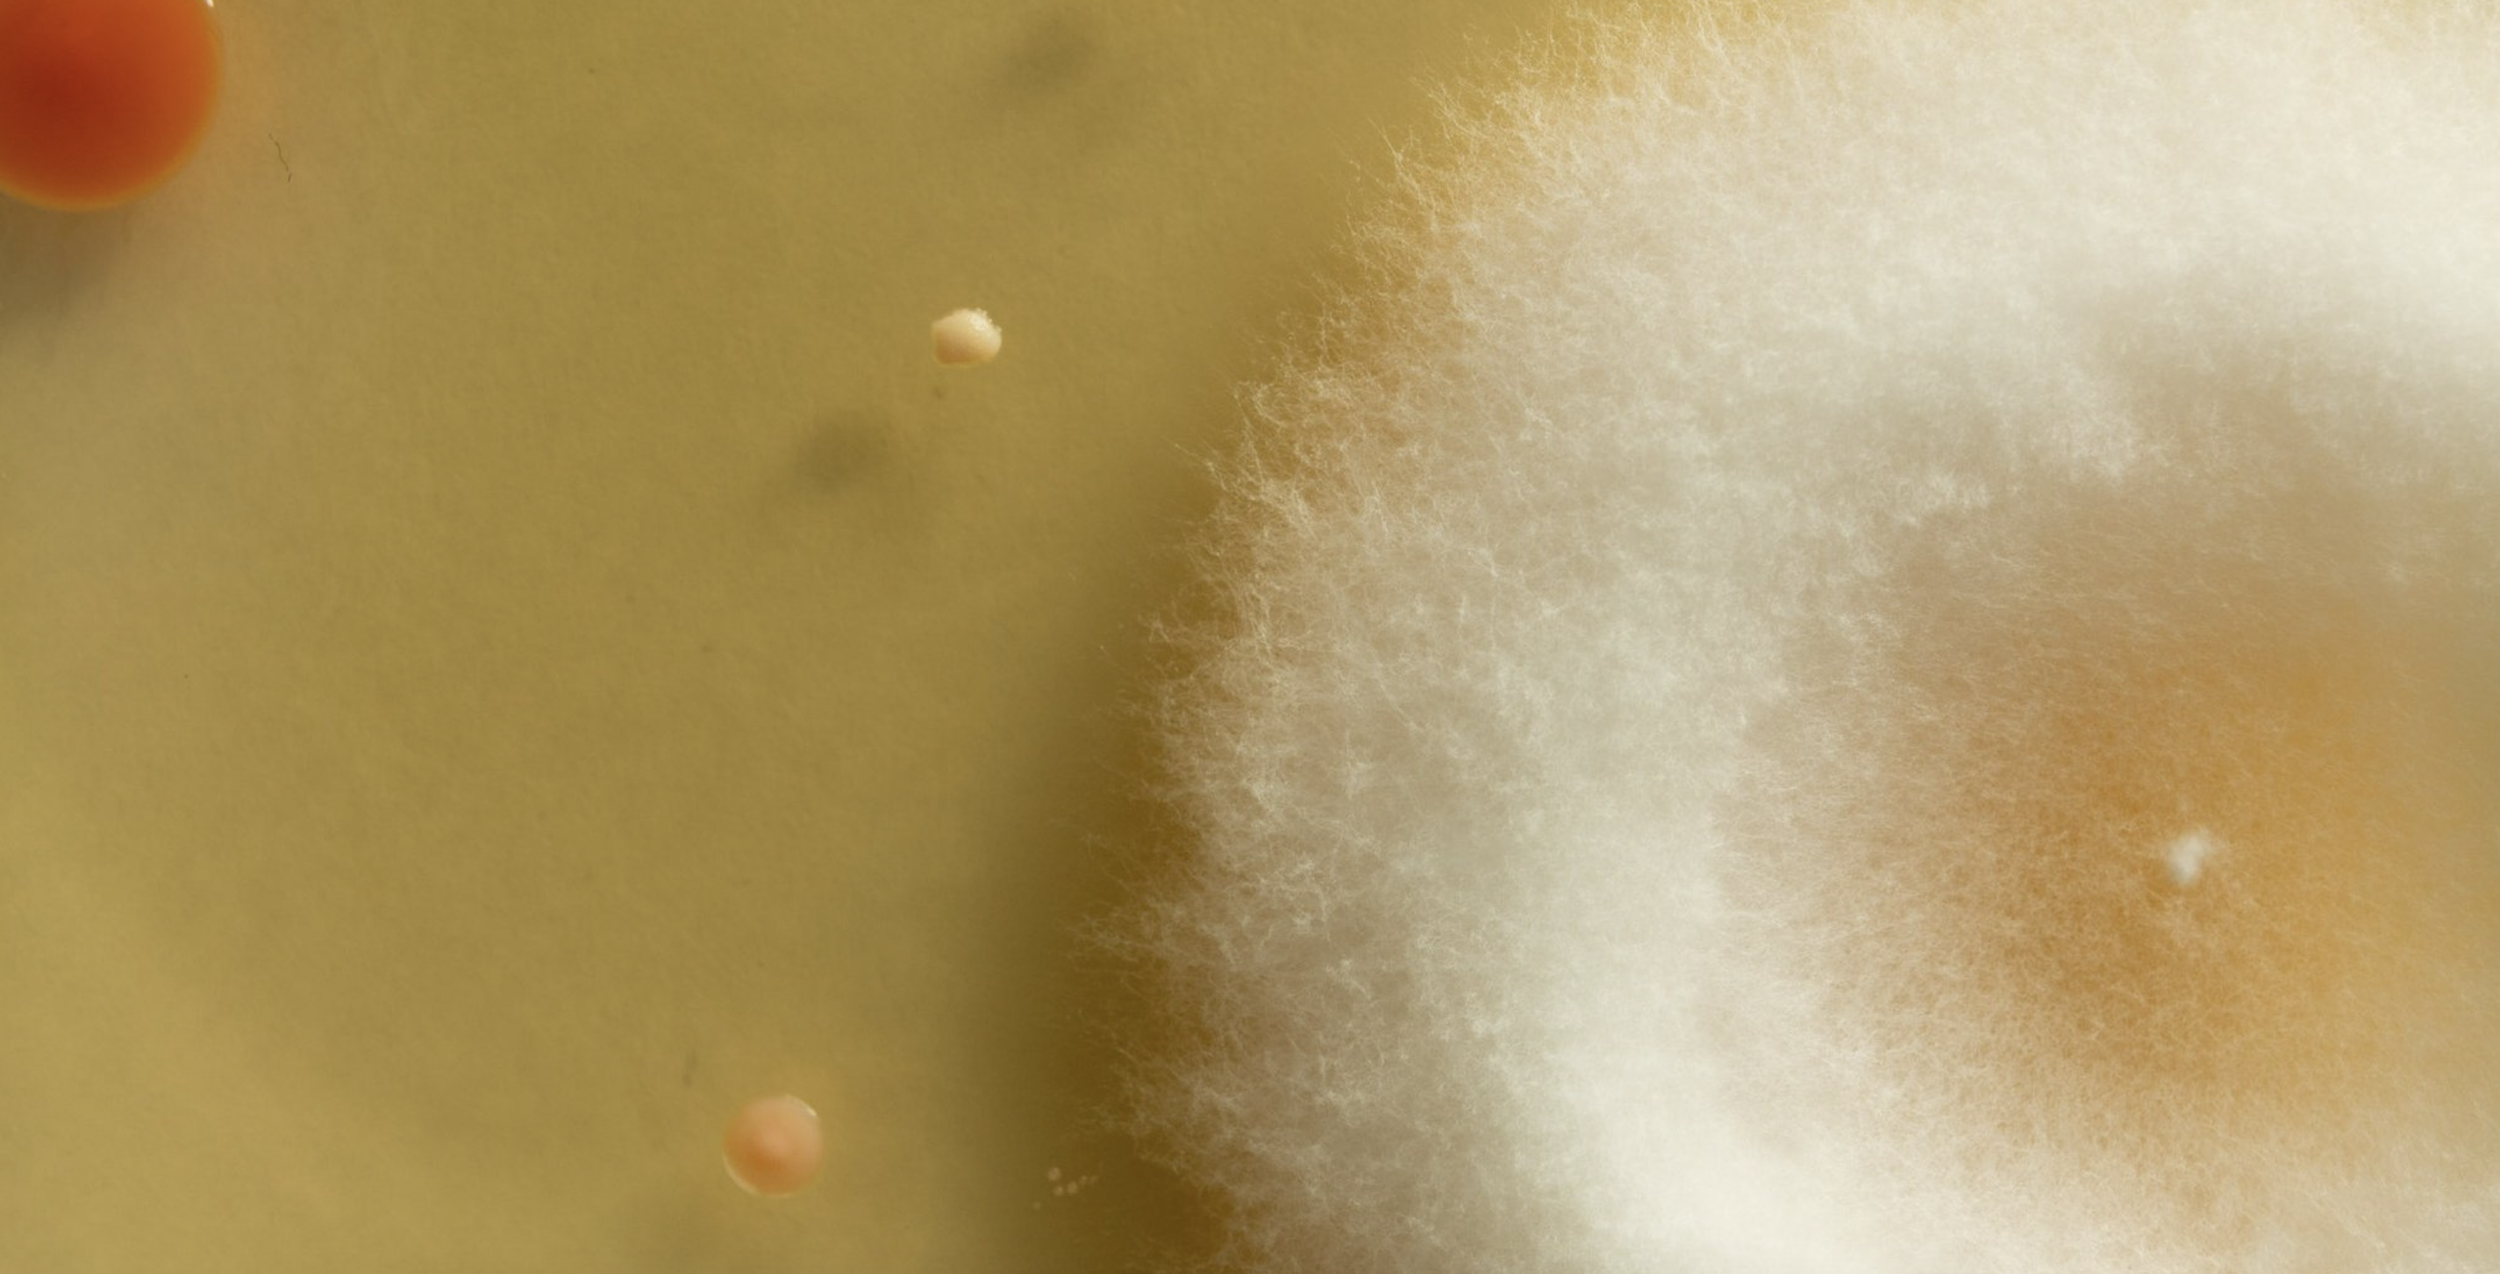

Sophie J Williamson
Image credits: Undead Matter, photo credit: Sam Roberts; (below) The Future Eaters (2022), Sophie J Williamson
Undead Matter is a multidisciplinary, collaborative practice initiated and convened by Sophie J Williamson, an artist, curator, writer based in London and Margate, that focuses on the blurred edges of life and non-life, focused on the intimacy of dying, and its dialogue with geology, ecology and planetary futures.
From a newly disabled body (imprinted by the shifting ecologies of the Anthropocene, after Williamson was bitten by a tick in 2023), Undead Matter is currently navigating unexpected outcomes from forced rest, unproductivity and learning about survival through crip allyship across species.
As Undead Matter, Williamson is currently Associate Curator (Art & Ecology) at the Natural History Museum, London (2025 – ) and has worked with BBC, TBA21, MACBA Barcelona, Tate and documenta, among others.
From 2013-2021, Williamson was Exhibitions Curator at Camden Art Centre, and was previously part of the inaugural team at Raven Row (2009–13). She was a resident artist at Jan van Eyck Academie (2021-22), and Curatorial Fellow at Banff Centre of Arts and Creativity (2020). Her writing appears in art magazines and journals (such as ArtMonthly, frieze, Elephant, October) and numerous exhibition publications and artist books. Her PhD at Goldsmiths College, University of London, titled Being-with-Dying: Living with Agency through the Anthropocene, is currently on pause due to chronic illness.